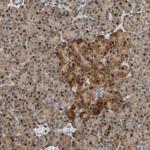
HECW1 Antibody in Immunohistochemistry (Paraffin) (IHC (P))

Search
Invitrogen
HECW1 Polyclonal Antibody
{{$productOrderCtrl.translations['antibody.pdp.commerceCard.promotion.promotions']}}
{{$productOrderCtrl.translations['antibody.pdp.commerceCard.promotion.viewpromo']}}
{{$productOrderCtrl.translations['antibody.pdp.commerceCard.promotion.promocode']}}: {{promo.promoCode}} {{promo.promoTitle}} {{promo.promoDescription}}. {{$productOrderCtrl.translations['antibody.pdp.commerceCard.promotion.learnmore']}}
产品信息
PA5-52457
种属反应
宿主/亚型
分类
类型
偶联物
形式
浓度
规格
纯化类型
保存液
内含物
保存条件
运输条件
RRID
产品详细信息
Immunogen sequence: STEPESAQIQ DSPMNNLMES GSGEPRSEAP ESSESWKPEQ LGEGSVPDGP GNQSIELSRP AEEAAVITEA GDQGMVSVGP EGAGELLAQV QKDIQPAPSA EELAEQLDLG EEASALLLED GEAPAS
Highest antigen sequence identity to the following orthologs: Mouse - 45%, Rat - 44%.
靶标信息
E3 ubiquitin-protein ligase that mediates ubiquitination and subsequent degradation of DVL1. Also targets the mutant SOD1 protein involved in familial amyotrophic lateral sclerosis (FALS). Forms cytotoxic aggregates with DVL1, SSR3 and mutant SOD1 that lead to motor neuron death in FALS.
仅用于科研。不用于诊断过程。未经明确授权不得转售。
篇参考文献 (0)
生物信息学
蛋白别名: E3 ubiquitin-protein ligase HECW1; HECT type E3 ubiquitin ligase; HECT, C2 and WW domain-containing protein 1; HECT-type E3 ubiquitin transferase HECW1; hNEDL1; KIAA0322; NEDD4-like E3 ubiquitin-protein ligase 1; NEDD4-like ubiquitin-protein ligase 1; unnamed protein product
基因别名: HECW1; KIAA0322; NEDL1
UniProt ID: (Human) Q76N89
Entrez Gene ID: (Human) 23072